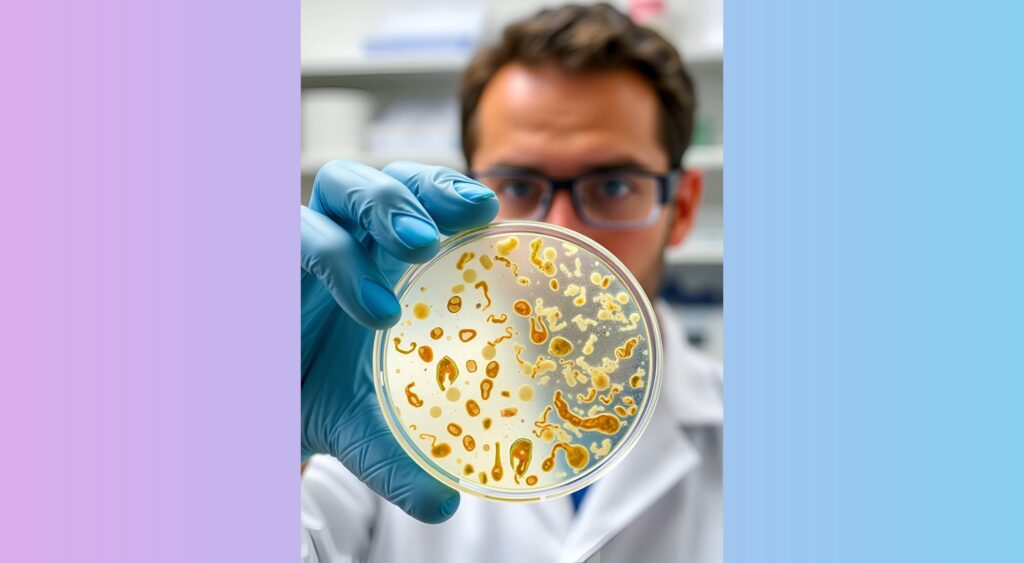
NEW CASE OF FLESH-EATING BACTERIA REPORTED IN LEE COUNTY

NEW CASE OF FLESH-EATING BACTERIA REPORTED IN LEE COUNTY
NEW CASE OF FLESH-EATING BACTERIA REPORTED IN LEE COUNTY
FORT MYERS BEACH, Fla. —
Health officials have confirmed a new case of Vibrio vulnificus in Lee County, marking the fourth infection reported this year, according to the Florida Department of Health (FDOH). The bacteria—often referred to as “flesh-eating”—is naturally present in warm salt and brackish waters and can infect people through open wounds or contaminated raw seafood.
Gulf Coast News spoke with beachgoers on Fort Myers Beach as word of the new case spread.
Terry Ruppert, visiting from out of town, said he’s now giving the water a second thought.
“I have a little cut kind of becoming a scab, but I would have thought about putting my feet in,” Ruppert said. “It is a little cooler today, so it’s not like I’m rushing in because I’m so hot, but it is definitely a concern.”
Rare but Serious, Experts Warn
While Vibrio vulnificus infections are uncommon, health experts stress that the consequences can be severe if symptoms are ignored.
Dr. Toshi Urakawa, a professor at Florida Gulf Coast University’s Water School, said beachgoers should not panic—but they should be aware.
“I’m very glad to see that people enjoy the beach and the beauty of the water in Florida. However, if you have something wrong, you should go to a hospital as soon as possible,” Urakawa said. “These issues have a high death rate.”
Regular Visitors Remain Cautious but Unshaken
Frequent Southwest Florida visitor Janice McCabe said she’s familiar with past reports of the bacteria, but it won’t stop her from enjoying the Gulf.
“I feel comfortable about it because, you know, I know these things have come up over the years,” McCabe said. “Honestly, we’ve got big family down here, and I don’t know anybody that’s ever come down with it.”
She told Gulf Coast News she sticks to seafood from reputable sources and keeps an eye on any cuts or scrapes.
Statewide Numbers for 2025
As of Dec. 5, Florida has recorded:
33 cases of Vibrio vulnificus
5 deaths statewide
No deaths in Lee County
The Florida Department of Health said specific details about where or when the most recent Lee County infection occurred are confidential.
Officials urge residents and visitors to avoid entering warm coastal waters with open wounds, wear protective footwear, and ensure seafood is fully cooked.